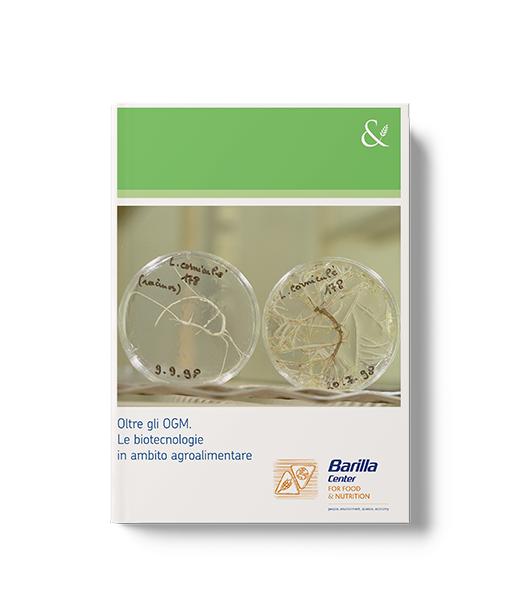

Saggistica
Libri, manuali, ricerche, inchieste, contributi originali di Autori qualificati ma anche di Enti, Istituzioni e Imprese, per disegnare lo scenario attuale della sostenibilità.
I testi possono essere cercati per Autore, per Publisher o per Tema.
Catalogo
Edifici e infrastrutture generano il 40% delle emissioni globali. L'accordo di Parigi e il Green Deal spingono alla decarbonizzazione, la Direttiva EPBD impone il calcolo della Whole Life Carbon. Una pubblicazione del Politecnico di Torino e GBG Italia fornisce strumenti per valutare e promuovere la Circular Economy nel settore.
Il volume propone una metodologia progettuale che considera ogni prodotto come sistema di componenti interconnessi, enfatizzando riparabilità e disassemblabilità per allungare il ciclo di vita, con esempi dal corso di Ecodesign del Politecnico di Torino.
Attraverso il racconto di quasi dieci anni di attività come parlamentare al Senato, Gianni Pietro Girotto illustra le sfide per ripensare le politiche industriali del nostro Paese in chiave green. Un resoconto dettagliato e, scrive l'autore, moralmente dovuto di quanto fatto e di quanto resta ancora da fare per il bene pubblico.
The effects of climate change on human health are gaining attention worldwide. Healthcare systems suffer these impacts while being responsible for 4.4% of global CO2 emissions: new sustainable solutions are urgently needed. MedTech is a key industry to drive this transition.
European Union project involving 12 partners to close the AHP waste cycle, reduce greenhouse gas emissions and develop the circular economy in Europe. An innovative integrated supply chain model for recycling this waste.
The Embraced project, funded by Horizon 2020, brought an innovative model for recycling AHP waste with separate collection, transformation into building rocks and applications from biomaterials to fertilisers.
Con questa pubblicazione i ricercatori di Kyoto Club individuano criticità e strategie adottabili verso l'azzeramento delle emissioni degli edifici in vista del 2050.
Curata da un gruppo di ricercatori in Design del Politecnico di Torino, Flowpack: il massimo col minimo è una pubblicazione scientifica strutturata per generare cultura sul tema del flowpack.
Edited by a group of researchers in Design at the Politecnico di Torino, Flow wrap packaging: the most with the least is a scientific publication structured to generate culture on the topic of flowpacks
These guidelines show how design choices for aluminium packaging affect recycling and sustainability, promoting a "closed loop" system and encouraging producers and users toward optimal, circular solutions.
Gli imballaggi nell'economia circolare
a cura di CONAI – Consorzio Nazionale Imballaggidicembre 2018
Il Pacchetto Economia Circolare europeo punta al 65% di packaging riciclato entro il 2025 e al 70% entro il 2030. Il report CONAI mostra i risultati italiani e traccia un percorso verso un futuro più sostenibile.
Il Capitale Naturale in Italia costituisce un riferimento imprescindibile per prendere consapevolezza di un tema fondamentale per le generazioni attuali e per quelle future.
Queste linee guida illustrano come le scelte progettuali degli imballaggi in alluminio influenzino il riciclo e la sostenibilità, promuovendo un sistema "closed loop" e stimolando produttori e utenti verso soluzioni ottimali e circolari.
Conference proceedings of the CNR-Institute of Amtospheric Pollution Research
a cura di Nicola Pirroneagosto 2018
The CNR Institute of Atmospheric Pollution Research held its 2018 conference showcasing its evolution, diverse activities, and impact on science, policy, and society. Its role in European programs highlights its expertise and contribution to environmental well-being.
Il littering
a cura di AICA – Associazione Internazionale per la Comunicazione Ambientalenovembre 2017
Combattere il littering, giorno dopo giorno, rifiuto dopo rifiuto con la forza dell'informazione. Linee guida e spunti pratici per costruire campagne di comunicazione e sensibilizzazione, per arginare un fenomeno che ci riguarda tutti: l'abbandono dei rifiuti.
Circular economy, benefits and good practices
a cura di Marino Cavallo, Daniele Cencioninovembre 2017
The EU's circular economy package sets waste reduction targets for 2030. This volume highlights business benefits, good practices, and key actors, based on Bologna's experience in the CESME project promoting circular economy among SMEs.
Il testo presenta un modello per il turismo industriale, valorizzando le imprese come mete turistiche. La visita d'impresa, parte di itinerari variegati, arricchisce l'offerta turistica integrando produzioni artigianali e industriali al territorio.
Il rapporto CIC evidenzia l'importanza della raccolta e trasformazione dei rifiuti organici in Italia, sottolineando il ruolo degli impianti e il potenziale del biometano. Nonostante la crescita, il settore ha ancora ampi margini di sviluppo per allinearsi agli obiettivi europei.
Ripartire da edifici, spazi infrastrutturali e agricoli peri-urbani abbandonati, dimostrando con i fatti che possono riprendere vita, trasformandosi in luoghi di partecipazione attiva e di comunità. Alcune esperienze italiane raccontate da Cittadinanzattiva.
In Italia, nonostante il patrimonio inutilizzato, si continua a consumare suolo per nuove costruzioni, penalizzando l'agricoltura. Serve un cambio di approccio, puntando su qualità, recupero e partecipazione comunitaria, come per il recupero dei centri storici, per uno sviluppo sostenibile.
NOW, led by CAUTO and supported by LIFE+, collects supermarket food donations to feed people in need, reducing organic waste and environmental impact. It fosters an inclusive circular economy and aligns with the EU's zero waste goals.
Che rapporto avete con la montagna? Uno studio condotto dall'Università di Bergamo su un campione di studenti delle province di Sondrio, Lecco, Milano: comportamenti, aspettative e percezioni del popolo degli escursionisti sul turismo montano.
NOW - No more Organic Waste racconta l'esperienza innovativa del progetto della cooperativa sociale Onlus Cauto di Brescia, che ritira i beni alimentari donati dalla GDO per convogliarli verso le associazioni che distribuiscono pasti alle persone in difficoltà.
Pratiche di sostenibilità vuole raccontare l’esperienza dell’omonimo progetto di Kyoto Club, che mira a diffondere i temi della sostenibilità ambientale attraverso la divulgazione delle buone pratiche esistenti nel nostro paese.
Pescarito: un'area industriale colpita da crisi economica e da problemi ambientali. Le possibili soluzioni in un caso studio per la gestione della zona per promuovere la creazione di aree produttive ecologicamente attrezzate.
Economica, duttile, resistente, igienica, leggera... è la plastica. Un materiale con un unico difetto: sostiene e concretizza lo spreco della società attuale, monomateriale. Un'inversione di rotta è indispensabile. Come? Recuperando il senso dei singoli oggetti.
Les bioplastiques: étude de cas de la bioéconomie en Italie
a cura di Kyoto Club, Walter Ganapiniaprile 2014
L'étude montre que la législation italienne de 2011 sur le sacs biodégradables a réduit de 50% l'usage des sacs jetables, favorisant le recyclage des biodéchets, l'innovation et le développement durable dans la bioéconomie.
Obiettivo comune analizza i nuovi processi di sussidiarietà, in cui il rapporto pubblico-privato passa da una dimensione verticale a una orizzontale, caratterizzata dall’individuazione di soluzioni alle problematiche pubbliche.
Per la loro valenza naturalistica le aree protette sono oggetto di un grande interesse turistico. Ma mentre si sviluppa il loro potenziale economico, emergono anche le difficoltà, come quella della gestione dei rifiuti.
I dieci racconti di questo volume sono stati selezionati nell’ambito del "Concorso di scrittura e immagine Cambiamenti Climatici – The Grand Challenge".
Un riferimento unico per la carbon footprint di prodotto stabilito dalla UNI ISO/TS 14067: tutti i cambiamenti implicati da questa Specifica Tecnica.
Bioplastiche: un caso studio di bioeconomia in Italia dimostra come una politica pubblica possa stimolare l’innovazione di processo e di prodotto lungo tutto il ciclo di vita e testimonia la possibilità di modificare le abitudini di consumo e favorire l’ambiente.
L’attività di ricerca illustrata è finalizzata allo studio di tecnologie impiantistiche innovative dal punto di vista energetico-ambientale al fine di individuare criteri di progettazione eco-compatibile.
La pubblicazione intende fornire spunti e idee ai soggetti, pubblici o privati, che stanno realizzando interventi finalizzati a trasformare o costruire una eco-area produttiva.
Rassegna di racconti frutto di un flashmob letterario in 500 minuti. Un tema comune: l'ambiente.
The Cartesio Network promotes innovative projects for the sustainable management of productive areas, like the ETA BETA project, fostering unified policies and practical tools for developing eco-productive areas in Italy.
In questo pamphlet, il coordinamento FREE affronta tutti gli argomenti evocati, snaturati e occultati dai sostenitori delle fonti fossili per denigrare la filiera italiana delle energie rinnovabili.
Bioplastics: A case study of Bioeconomy in Italy provides a no-nonsense case in support of public policies that modify consumption patterns, contribute solving environmental issues while stimulating product and process innovation all along a product’s life-cycle.
Un excursus semplice, immediato e divertente con consigli e suggerimenti su come cambiare i nostri comportamenti per adottare stili di vita più sostenibili e sul perché è indispensabile farlo subito.
Il fare ecologico propone un'analisi dell'evoluzione dei processi produttivi verso un migliore e più efficiente utilizzo delle risorse impiegate.
Il volume mette insieme per la prima volta tutti gli elementi che definiscono questo fenomeno, analizzandoli con le lenti della psico-sociologia, dell’ecologia, della normativa, dell’economia e della comunicazione.
Per sfatare una convinzione errata non è sufficiente riempire la testa della gente con informazioni corrette... È dura cambiare la testa della gente, e questo libro spiega perché.
LombardiA+ presenta 29 casi di edifici a consumo quasi zero realizzati in Lombardia e mette in luce l'importanza della certificazione energetica come strumento di informazione per i cittadini.
I rifugi alpini del Verbano-Cusio-Ossola verso un turismo sostenibile
a cura di Riccardo Beltramo, Stefano Dugliosettembre 2012
Una ricerca molto nutrita e argomentata sulle nuove frontiere del turismo sostenibile in alta quota.
Photovoltaics are desirable not only from an environmental perspective, but also from an economic one. Drawing of the experiences of Germany, Japan, and California, this work offers an analysis of photovoltaic technology and its diffusion.
È possibile misurare il benessere? Quali le variabili da prendere in considerazione per strutturare un sistema di indicatori valido, in grado di comprenderne i diversi aspetti?
155 milioni di bambini obesi nel mondo e, di contro, 148 milioni di bambini denutriti. Un'analisi dei fattori che determinano tale squilibrio.
Nel mondo un miliardo di persone soffre la fame e un numero equivalente di individui è obeso o in sovrappeso. L'accesso al cibo è questione complessa e articolata.
Come le innovazioni tecnologiche possono rispondere alle sfide del settore agroalimentare? Quali le implicazioni e quali le regolamentazioni necessarie?
L'acqua è una risorsa limitata. Nello studio si analizzano realtà e prospettive del diritto all'accesso all'acqua e si passano in rassegna scelte e comportamenti per un consumo sostenibile.
Quali sono le variabili chiave che determinano il costo del cibo? Un'analisi dei diversi fattori che incidono sulla volatilità dei prezzi in un quadro metodologico ampio e rigoroso.
Gli impatti ambientali delle scelte alimentari: la doppia piramide – l'una che identifica le proprietà nutrizionali degli alimenti, l'altra il loro impatto sul nostro Pianeta – dimostra come un'alimentazione sana sia anche sostenibile.
Qual è il ruolo dell'alimentazione rispetto alla longevità e al benessere della popolazione? Un'analisi del rapporto tra corretta alimentazione, stile di vita e longevità.
Il settore agricolo ha impatti ambientali elevatissimi. È necessario continuare a lavorare affinché la produzione agricola sia sempre più sostenibile: nuovi modelli non sono solo possibili, ma assolutamente necessari.
Rassegna di racconti frutto di un concorso letterario nazionale sui cambiamenti climatici.
“Lester Brown ci indica come costruire un mondo più giusto e salvare il pianeta, in modo pratico e diretto. Dovremmo tutti seguire il suo consiglio.” Bill Clinton, ex presidente USA
Oltre 12 miliardi di euro di prodotti agroalimentari finiscono direttamente nella spazzatura. Una quantità di alimenti ancora buoni che potrebbe sfamare quasi un’altra Italia.
Rapporto per l'anno 2009 sulla sostenibilità dell'impresa nata a Parma nel 1877 a partire da indicatori e valutazioni su filiera, ambiente, risorse umane, persone, comunità e stakeholder.
Il testo sottolinea l'importanza della Mediterraneità come stile alimentare e culturale unico, oggi minacciato dall'abbandono della dieta mediterranea tradizionale. Urge tutelare questa eredità per preservare salute, socialità e valori storici del Mediterraneo.
The text emphasises the importance of the Mediterranean Way as a unique food and cultural style, now threatened by the abandonment of the traditional Mediterranean diet. There is a urgent need to protect this heritage in order to preserve the health, sociality and historical values of the Mediterranean.
Gli OGM in campo agroalimentare: problemi, soluzioni, opinioni. In che misura la tecnologia può fornire risposte ai problemi legati all'alimentazione per tutti, alla sicurezza alimentare, alla salute e alla sostenibilità di un intero settore?
GMOs in agri-food sector: problems, solutions, opinions. To what extent can technology provide answers to the challenges related to food for all, food security, health, and the sustainability of an entire sector?
Accesso al cibo: quali le implicazioni e le ricadute? Come bilanciare la necessità di tutelare la salute umana con la dimensione socio-politica?
Access to food: what are the implications and consequences? How can we balance the need to protect human health with the socio-political dimension?
Alimentazione e salute: implicazioni, indicazioni per la prevenzione, prospettive.
Nutrition and health: implications, guidelines for prevention, perspectives.
Il BCNF Index: l'indicatore proposto dal Barilla Center for Food & Nutrition per la misurazione del benessere delle persone. Caratteristiche, fattori, implicazioni.
The BCNF Index: the indicator proposed by the Barilla Center for Food & Nutrition for measuring people's well-being. Characteristics, factors, implications.
The Environmental Impact of Food Choices: the Double Pyramid – one identifies the nutritional properties of foods, the other their impact on our planet.
Gli impatti ambientali delle scelte alimentari: la doppia piramide – una identifica le proprietà nutrizionali degli alimenti, l'altra il loro impatto sul nostro pianeta.
Il rapporto tra alimentazione e salute dei bambini, con linee guida per un'alimentazione e uno stile di vita corretti.
The relationship between nutrition and children's health, with guidelines for proper eating habits and lifestyle.
Dal rapporto cibo-cultura nella vita pratica, spirituale e sociale all'influenza delle tendenze socio-culturali sull'alimentazione contemporanea: un vasto excursus sulla dimensione culturale del cibo.
From the relationship between food and culture in practical, spiritual, and social life to the influence of socio-cultural trends on contemporary eating habits: a comprehensive overview of the cultural dimension of food.
Il libro illustra nel dettaglio le soluzioni più semplici e innovative per il risparmio e la migliore gestione dell’acqua nelle abitazioni e in città , proponendosi come la prima e più completa guida all’uso sostenibile delle risorse idriche.
La riduzione delle emissioni di gas climalteranti può diventare opportunità di sviluppo economico? Certamente sì, con ricadute positive in termini occupazionali e sull'economia in generale. Una sfida da cogliere.
Con chiarezza e abbondanza di argomentazioni, il testo di Cass R. Sunstein rivendica la necessità di un’analisi razionale del rischio ambientale, e di una sua comunicazione corretta al pubblico.
La registrazione è gratuita